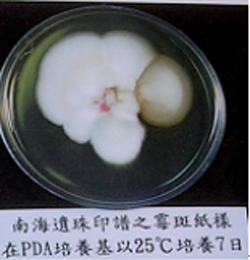

圖書水淹處理與光害防治
楊時榮 國立中央圖書館臺灣分館編輯
【提要】本文為「紙質圖書保存維護管理研習會」之「圖書水淹處理與光害防治」單元課程實錄,內容主要概介圖書水淹處理與圖書光害防治兩主題。一、圖書水淹處理:介紹水淹災害的種類、防治、災後的緊急處理及兩個圖書館水淹書的搶救案例。二、圖書光害防治:介紹光的產生、光的波長、光對纖維抗張強度的破壞、光的照明單位、圖書館的光照標準、圖書館的光害防治。
關鍵詞:圖書維護;圖書修復;圖書劣化;水淹書;黴菌;光;紫外線
壹、圖書水淹處理
圖書館發生水淹災害的種類有哪些?如何防治?如果預防和防治沒有成功,圖書遭受傷害,要如何緊急處理?如何修復?這是本課程主要介紹的四個範圍;接著再介紹兩個圖書館水淹書搶救案例。
一、水淹災害的種類
一般圖書館發生水淹災害的種類大概有二種,一種是自發性的,另一種是侵入性的。
(一)自發性的水災
所謂自發性的水災,一般指的就是館內建築發生的問題,如水管破裂、冷氣冰水管結露滴到書上、排水管堵塞,還有如火災發生時,消防救災所噴灑的水,這些都會造成圖書館水淹書。所以,大家很納悶二樓怎麼可能會水淹書?事實上有許多淹水的情形,都是發生在二樓以上的樓層,如果樓板有偷工減料,不是很密實,淹水也還會從樓板滲透到下一樓層,這都是平時常看到的事情。
記得在臺灣分館舊館時期﹙新生南路時期﹚,二、三樓書庫就曾經有淹水的事情發生。當時因為有工讀生在三樓書庫整理書籍,從書架間的樓梯跳下來,剛好跳在冷氣的冰水管上,把水管弄斷了,整個三樓就淹水,並往下面樓層淹水。還有一次是國立藝專(現稱國立臺灣藝術學院)的新圖書館完成時,也淹了兩次水。一次在颱風天,地面一樓的排水管堵塞,樓頂的水排不出去,就從二、三樓的排水口冒出來,所以存放大陸圖書的開架書庫也就淹水;另外一次是因為水塔馬達的電源開關設在讀者閱讀區,早上學生很早來想先看書,將電燈的電源開關全部打開,但同時也無意間將樓頂水塔自動抽水馬達的開關給關閉了,結果馬達因為無法自動控制,便一直抽水,使得水塔的水溢出,順著樓梯一直往下淹,從樓上淹到樓下來。除了以上這些實例外,自發性的水災還有其他的因素,如一個假火災,觸動火災警報系統自動灑水下來,或救火時,從外面噴水柱進來,同樣都會造成圖書館部分區域水淹書的情況發生。
我們都知道有的冷氣會有冰水管的設計,當庫房室溫二十幾度時,冰水管因為溫差在5度以上時,水管表面就會結露,並往下滴水,如果滴水的位置是可以用水桶接到的,也就還好;可是如果是滴在書架上方,則後果便會堪慮,若水滴落在書上,整個書就會長黴,書頁紙張便會被黴菌分解。曾經在館內有一本書被水滴到,發現的時候,那本書有一部分已經被黴菌分解了,分解的程度是大家無法想像的,因為黴菌要分解紙張是要吃紙張上面的蛋白質、澱粉之類物質,所以黴菌必須先要分泌一些酶素來將蛋白質或澱粉分解,分解後的紙張就只剩下纖維,書就像一團棉花。雖然滴水事情是個小災害,但若不注意它,就會釀成一個不可挽救的事實。
又,書庫地上擺放書籍,此時除濕機若接水管線沒有接好或接水桶沒擺放好,除濕的水便會漏流到地面,沾濕地上的書。
所以,從這些情形看,圖書館自發性水災的發生,很多都是讓人意想不到的。
(二)侵入性的水災
所謂侵入性的水災,就是整個建築體結構不是很完善,有一些漏洞,一下雨或遇到某些風災的時候,因為外面和裡面的壓力不一樣,就會把水氣擠進來,或者是外部的水透過某些媒介進入建築物內部。
1. 窗戶氣密不足
平時窗戶不會漏水,可是每次遇到颱風天,窗台的水都會擠進來。那是因為颱風天,建築物裡、外的壓力不同,而把水氣擠壓進入庫房內部,按進入水氣的多寡,也可判知窗戶氣密程度的良窳。
2. 風管破裂
有些書庫為了內部空氣流通,會在樓頂安裝抽風機,及連接通風管至庫房,但如果樓頂的風管年久失修接口生鏽,此時若遇到大雨天,水就會順著風管鏽口流入庫房內;這在臺灣分館新生南路舊館時期也曾發生過,最後是把樓頂抽風及建物外部風管全部拆除。
3. 頂樓板漏水
頂樓板漏水是常見的,不只是圖書館,一般家庭也會發生頂樓板滲水的問題。
4. 外牆滲水
如雨天,水從外牆滲進來,常會造成書庫內部地面積水或牆面潮濕,如果沒注意到,而持續發生,水淹及潮濕範圍會愈來愈大,整個書庫濕度也會隨之增加而滋生黴菌和蟲害,圖書的危機也就由這裡默默發生。
5. 其他
上週臺北強颱壓境,我住家的地方因位在山區,所以風速超強,夾雜著很多磚頭、瓦片,把某鄰居房屋的帷幕玻璃(強化玻璃)牆全部打碎,鄰居家中的隔間、浴室、客廳、傢俱由屋外向內看,全部一覽無遺。這給我們一個很大的啟示,就是書庫的建築,如果只是一味地講求美觀,而忽略了安全性,則災害發生的機率就會隨之增高。假如有一天圖書館因颱風天,窗戶被打壞,而書籍正好擺放於窗戶邊,那麼書架和書籍所遭受毀損的損失,將是難以估計的。所以,這是屬於侵入性的水災。雖然帷幕玻璃可以抗壓,可以抗風,但是如果風夾雜著一些堅硬的東西,那就不是膠合或強化玻璃能抗幾級風的問題了。像我家的玻璃屋是18級風都沒有關係的,可是就只是一個小玻璃隨著風夾雜吹打下來,就把強化的塑膠板打了一個大洞。所以,風帶動硬物的力量比風本身的力量更大。因此,館舍建築時,注意書庫位置的安排、安全性等,這些都是一定要考慮的;若沒有這些考慮,將來所面臨的狀況,就會有很多的擔憂。
二、水淹災害的防治
水淹災害要如何防治呢?就如前面說明的,要做好預防性工作,要將會發生水淹的原因事先排除掉、要建立防堵外部侵入之措施、要加強居安思危的警覺……等預防措施,則圖書遭受水淹的機率便會降低。水淹災害防治的範圍包括:
(一)排除內部肇因
預先將會知道淹水的狀況排除掉,則淹水的機率自然就會降低。例如:規畫圖書館庫房,儘量不要讓整棟樓層的排水管集中於一條管路,最好能將書庫的排水管獨立出來,即使底層水管堵塞,上層書庫也不會淹水;庫房內存在的冷氣冰水管,儘量遷移到旁邊,以免因溫差產生的滴水,造成圖書損傷。
(二)建立防堵外部侵入之措施
例如前面提到鄰家慘不忍睹的玻璃屋,可以用磚把它砌起來,把窗戶開小一點;將會滲水進來的風管拆除,或隨時保養風管,注意是否漏水;以及加強窗戶的氣密性,不要讓水進來;還有大門口的一些防範措施,如裝置雨傘架、吸水踏墊、雙重氣門……等,都是能夠防止外物侵入和減少水氣進入室內的機會。
(三)加強居安思危的警覺性
前面兩項都做好了,並不保證不會淹水,要有居安思危的警覺性,隨時巡視書庫、館舍是否有淹水的可能性。如成立一個危機處理小組,隨時開會檢討:電線是否太老舊、會不會引起火災,或建築物是不是破舊,會不會因颱風天而遭受破壞……等,這些都是要建立在居安思危的警覺性及機智性的管理上。
(四)移藏
如果前面三項都完成,可是書庫還是每年淹水,最後只有做第四項,那就是儘快把書庫遷移、遠離禍端,因為這是最有效及唯一的解決方式。例如臺灣分館在民國六十年代新公園時期(現稱「二二八公園」),當時就有一個遷館計畫,臺北賓館(現位於總統府斜對面)便是一個選擇對象,最後評估沒有遷移的原因,是因為臺北賓館是一棟木造的日式建築物,評估以後,發現裡面有很多白蟻,即使每年除蟲,白蟻還是生生不息,所以就直接在新生南路蓋新館,這就是一個轉移地點遠離災難的選擇方式。
三、水淹災後的緊急處理
如果上述的預防工作都已經做好,但水淹書的災難還是發生,那麼我們要如何處理?在國外有先進的科技,處理水淹書一般都用真空冷凍的方式,進行水淹書的脫水和乾燥,但是在臺灣目前沒有這種大型設備,所以大量水淹書是不能採用這種方式。不過,現在臺灣分館有一套大量除酸設備,它的附加價值雖然也是可以採真空方式處理水淹書,但因臺灣南北路途遙遠,若是中南部水淹書送到北部處理,亦是緩不濟急。所以,本次的研討範圍,就用傳統的緊急處理程序及方式,作為主軸,說明如下:
(一)判定淹損狀況
首先要判定淹損的狀況。我們要先了解圖書、設備、環境,以及遭淹損破壞的程度,是整個圖書館都被水淹、還是局部的遭受水淹、或是極輕微受到水淹,然後再決定處理的方式。
(二)決定處理方式
依照前述判定淹損狀況後,再決定處理方式;一般有原址處理及移出處理二種。如果書庫內只有一、二個書架被水滴到,在這種輕微受損的情況下,就可以考慮原址處理的方式;如果是全面的,像納莉颱風把整個圖書館淹到半個人的深度,當然就要採取移藏的處理方式,將水淹書移到其他乾燥、空曠的地方處理。
(三)原址處理原則
原址處理,主要是處理輕微的水淹書,如整個大環境只有幾本書被淹到,就可以在原來的地方處理。一般而言,處理的方式可從兩方面來做,一是書籍除濕,另一面則是現場乾燥。所謂現場乾燥,就是在淹水現場清潔乾淨、乾燥。而書籍除濕和現場乾燥的方法,是以冷氣機、除濕機、空氣對流機、抑黴劑或內外空氣自然流通等方式,除去圖書濕氣及防止黴菌滋生。由於冷氣機本身就有除濕的效果,如果持續保持在濕度22度或23度時,黴菌是不容易生長的;而除濕機可以快速地除去空氣中的水分,讓書籍可以慢慢乾燥;或是用空氣對流機讓空氣對流,使黴菌不易滋生。
然而處理水淹書,最怕的是書籍長黴,書籍長黴以後,要花很多的時間和精力去處理。就我的經驗來講,只要像納莉、象神等級的颱風,整個書都被黃泥巴水淹到,大概要在兩天之內處理搶救,因為整個環境充斥著水氣及黴菌,48小時以後,書籍就會慢慢冒出黴菌,連菌絲都會長出來。另外,書籍除濕時,如果只有幾本遭受輕微水淹,宜於小空間處理,除濕速度則會較快;如果是整本書都淹濕了,可採取微波燥熱方式循序漸進處理,但是用微波爐處理時要特別小心,不可以快速方式,將書微波乾燥,因為快速乾燥,乾燥會不均勻,會造成嚴重後果,書籍三邊的開書口會全部乾燥沾黏在一起,書的中間卻還是會有些許潮濕。所以,用微波爐處理潮濕的書時,需要採取循序漸進的方式,如第一次放進去使用3秒或5秒的時間,除去書籍部分的水分,書的開書口都沒有沾黏,把書拿出來,讓書纖維上的水分互相地滲透,讓它均勻平衡以後,再將它放進去,反覆地處理5、6次,書大概有百分之六、七十乾燥時,就不必再用微波爐處理了,因為書籍要長黴菌的機率已經比較小,只要控制好處理環境中的溫度和濕度,應該就不會有黴菌發生的問題。
如果書的水淹數量少,為了不要讓它長黴菌,也可以將它放進冰箱冷藏。但不要放到冷凍庫,因為在國外冷凍脫水,是要有真空設備配合:把書籍結成固態的冰塊後,放入真空室後,再利用真空低壓的低沸點,馬上使固態成氣化,這是由固態的冰塊直接變成氣態離開書籍,所以對紙張損壞不大。如果沒有真空設備,把書籍的含水結冰,當要把書拿出來處理時,又要從固態冰轉化成液態水再變成氣化,此處理方式不但會花較多時間,對書頁紙張的收縮損傷影響也會比較大。
至於書庫空氣對流的方式有很多種,其中開電扇吹便是其中之一。臺灣分館中和新館二樓參考組的書架底部,設計離地20公分,不但讀者容易取拿書架最下層的書籍外,庫房空氣也易對流,書架下的塵垢也易清掃。書架底部離地面越近,越易藏污納垢及阻礙空氣對流;如故宮圖書文獻處庫房書架,離地面大概也有30公分高。所以,書架離地面高,應該是圖書維護的一個新趨勢。庫房內外空氣對流的重點,是在空氣自然流通時,須注意戶外空氣濕度要小於室內,才可採用此方式。而空氣對流方式對書籍快速乾燥的效果也是蠻大的。
(四)移出處理原則
在書庫遭受嚴重淹水,整個書庫環境處於潮濕髒污的情況下,書庫內的水淹書是要移出處理。移出處理的方式,有圖書文獻移出分類處理及現場清潔乾燥二種。移出處理水淹的書籍,可依水淹程度的輕重及書頁紙張的材料,予以分類集中移出處理。移出處理之書籍,分為銅版紙類及一般圖書文獻(模造紙、道林紙類)兩部分,然後再由此兩部分各自分成兩類,分別為嚴重類水淹書及輕微類水淹書。水淹書移出後,要將水淹庫房之現場清潔、乾燥及消毒。
選擇移出處理之場地,條件需乾燥、通風、面積寬敞、空間不宜太高、動線出入方便、有電源。因為環境太高的地方,除濕空間也大,相對的除濕設備也就要多,才能把環境和圖書的濕氣除掉。至於動線一定要出入方便,因為要運書、搬書、進書、人員進出等瑣事,都是非常頻繁的。同時處理水淹書時,需要使用很多的電器,所以處理場地也需要有足夠的電力及電源插座。
處理的方法和上一項原址處理原則一樣,是以冷氣機、除濕機、空氣對流機、抑黴劑或內外空氣自然流通等方式,除去圖書濕氣、防止黴菌滋生及移出後之原址乾燥。書籍移出分類,先挑出銅版紙類及一般圖書文獻,然後再挑污損嚴重和輕微污損,分別集中處理。銅版紙類及污損嚴重圖書,應與輕微除濕書籍分開空間處理。
(五)移出處理案例
以霧峰林家地震災後的水淹文獻處理為例,霧峰林家在921大地震後,很多臺灣文獻全部被震埋在瓦礫中。在修護房子挖掘瓦礫時,才發現瓦礫中埋藏了很多臺灣第一手的文獻資料,所以就向中研院近史所求救。中研院近史所胡雪姬教授便請我帶她的研究生去搶救,當時張豐吉教授也有協助處理。搶救的方式,主要是將這些瓦礫中潮濕的文獻資料分門別類地裝進袋子,例如乾燥的、潮濕的、嚴重長黴的及輕微長黴的分別集中裝袋。每個袋子都用抑黴劑噴灑消毒,讓文獻在移送的過程中,不會那麼快速長黴。
水淹書最忌諱曬太陽,因為紙張纖維被污水浸泡後,吸水性會變差,經過太陽曬,因為紙張經陽光中的紫外線照射後就易脆劣。所以,這時的處理方式就是將書放進袋中後,用冷藏的方式,運回臺北處理。這批資料目前存放在近史所,全部都已經清洗、修復完畢。
(六)一般紙類圖書的移出除濕
一般紙類圖書的移出除濕,以小立體空間處理。輕微受濕書籍以冷氣機、除濕機、空氣對流機、抑黴劑或內外空氣自然流通等方式除去圖書濕氣。嚴重受濕書籍,則可採取微波燥熱方式,循序漸進處理書籍至微潮的階段後,再與輕微受濕書籍同步自然除濕,待書籍乾至九成後,則可移回書架緊壓防止書籍嚴重變形。
修護常會有個困擾,就是常常會使用到化學藥劑,而很多化學藥劑對紙張都會有所破壞,前面張豐吉教授也提到,甚至於紙張的添加物對紙張本身都會是一個破壞,所以在處理圖書文獻修復時,能不能使用化學藥劑來處理,到底我們要不要使用化學藥劑?這就是一個抉擇的時候。如果使用它,原件資料可以維持100年;若不使用它,原件資料只能維持10年。要不要使用化學藥品?只有主事者自己去判斷了,這是沒有絕對正確或絕對錯的事情。大家常會想,水淹書乾後書頁會皺,所以處理水淹書時,書籍到八、九成乾的時候,就要用重壓的方式將它壓平,這時紙張不會沾黏在一起,圖書也會比較平整,書頁不會皺得亂七八糟,而且書背也不會被破壞掉。切記!書庫環境控制的好,圖書長黴的機率就會低。
(七)銅版紙類圖書的移出除濕
銅版紙類圖書的移出處理,必須要有一個很大的空間,因為每一本水淹書都要逐頁翻開夾紙,避免書頁沾黏,至全書乾透再處理。銅版紙在還沒沾黏時非常好處理,一旦沾黏後是無法打開很難處理的。而銅版紙封面的書,也是比照銅版紙類圖書方式處理,尤其是期刊合訂本。
(八)銅版紙類水淹書處理案例
以臺北市立南港國民小學第五十四屆畢業紀念冊修復實例說明。該書在象神颱風肆虐後一個月,才進行修復處理,當時書身尚未全乾,還有一些水氣,所以採取前述方式,於書頁中逐次夾入隔紙,防止書頁沾黏,待書本全乾後,再進行清潔、修復等工作。修復程序圖示如下:
| 1. | 水淹長黴情形:封面紙板是馬糞紙,整個都是黴菌,且已經爛掉了,所以將整個封皮拿下來。  |
| 2. | 首先將黴爛圖書封面與書身拆離,再將封面紙板拆除,並陸續揭開書身各頁及墊入隔紙,以防止書頁再度沾黏,待書頁乾透後,再逐頁以濕棉巾輕拭書頁,除去泥漿和黴菌。 |
| 3. | 書頁拭淨後,需將裂損處予以修補。 |
| 4. | 書頁全部拭淨修補完成後,再將背脊貼紙拆除在拆除過程中須注意避免把綴線拆斷,要保留綴線、線頭完整,以免破壞書身結構。 |
| 5. | 再按照書背脊長寬裁切相等牛皮紙一張,作為背脊貼紙。 |
| 6. | 將書身上下以木板夾住,露出書背些許。 |
| 7. | 然後於背脊處刷上白膠(pH8.5),刷膠時要把線頭整個埋在書背裡面。以前都用骨膠,後來發現動物性的膠很容易氧化、脆化裂掉,所以用植物性的膠比較柔軟,維持久一點。 |
| 8. | 將牛皮紙條,黏貼於背脊白膠上並以乾布抹平,上置重物壓住固型。書身的處理就完成了。 |
| 9. | 將拭淨後之封面平舖,封面紙因淋膜有塑料層,部分封面紙已有脫離現象。 |
| 10. | 將平舖之封面覆蓋潮濕毛巾,以使封面紙平整。 |
| 11. | 依封面舊紙板尺寸,裁出新封面紙板兩片、背脊紙板一片。 |
| 12. | 將新紙板黏貼於平整後之封面紙背部。 |
| 13. | 黏貼紙板後,順便將封面撕裂處對齊修復,並用乾布將封面紙拭平。 |
| 14. | 再依書身尺寸裁出對折蝴蝶頁(就是書籍前、後和封面連接起來的紙)兩份。 |
| 15. | 將蝴蝶頁黏於書身前後。 |
| 16. | 上書封,將書身封面套對整齊。 |
| 17. | 並於背脊處刷上白膠。 |
| 18. | 封面與書身上膠黏合後之情形。 |
| 19. | 膠黏合後之圖書,還須以重物壓緊固型。 |
| 20. | 壓乾固型後,尚須逐頁翻閱檢視。 |
| 21. | 修復後情形之一 |
| 22. | 修復後情形之二 |
| 23. | 修復後情形之三 |
(九)嚴重水淹污損資料的處理方式
處理很嚴重污損的資料,因為要處理修復、漂白、脫酸的實務性作業,所以需要選擇一個大且空氣流通的場地。處理方式有全書去污或重裝處理,一般嚴重的污損,都是全書去污,必須要把書籍拆解以後來做,待做完後再重裝,處理這一部分時,一定要有水、電,最重要的是要有防毒物的措施,如修復桌要有吸附黴菌的罩子及集塵措施,可以將吸附黴菌收到集塵袋裡,修復人員清潔髒污書籍時,需要戴口罩,如N95口罩,因為黴菌對人體內傷害非常大。
修復的步驟:嚴重的書籍文獻可以分為兩部分來講,一種是整冊圖書的處理方式,另一種是單張文獻的水淹處理。
1. 整冊圖書的處理方式
以《南海遺珠印譜》為例說明。這本書是國立中央圖書館臺灣分館於民國七十九年六月編印發行的,長24.6公分、寬13公分,共72面。原裝訂形式為軟面平裝、方背平脊,書身書組以膠訂背,書頁採用線裝書方式折頁,前後無蝴蝶頁。過去並未有修復跡象。現在遭受象神颱風黃泥水淹泡,而使得封面及書頁表面遭受嚴重泥污和50%黴害滋生,書籍膠裝部分也有裂損現象。修復過程中,採取去污、漂白、脫酸等方式處理。
(1) 拆裝:首先將書身、封面分離,再將書頁一張張揭離背膠。 (2) 去污:封面及書頁沾有之泥污、黴菌,需60℃清水淋洗。 (3) 漂白脫酸:書頁以次氯酸鈉、硫代硫酸鈉漂白,再以碳酸氫鎂脫酸。封面因為是紅色的,不漂白脫酸,只採60℃清水淋洗。 (4) 修復方式:依原方背平脊形式修復,書身裝訂原為膠裝,修復後因書頁無法採取訂背方式綴訂,故改採三孔打穿式綴訂。
另外,黴斑檢測及電顯照相資料,係委託夏滄琪博士處理。本書黴斑區之pH檢測分析,黴斑區以藍色表示,空白區域以紫色表示。由pH檢測分析發現淹水的書pH值最高都4點多,屬於酸性的。

還有對黴斑處理前後之白度檢測。洗後的白度恢復到紙張一般的白度。漂白以後也恢復了正常的紙張白度。

我們再把書上長黴斑的紙,取樣在培養皿培養,放大後發現都好漂亮,但對紙張纖維的損害卻是很大的。

有黴斑部分的纖維,都有附著一些黴菌在上面。


沒有黴斑的纖維,都蠻正常、健康的。


接著是漂洗脫酸與裝訂:
| (1) | 污損情形:書籍都皺起來長黴。  |
| (2) | 將書籍的書身和封面揭拆後,分兩部分來處理。封面墊一塊棉布,以60℃清水淋洗,用軟毛刷一直刷到封面紙張乾淨。 |
| (3) | 書頁浸潤、漂洗、脫酸情形:封面刷清潔後,接著就是漂白。漂白有幾個程序,第一是用蒸餾水將紙張浸濕透後,再放到漂白水裡,因為濕透以後浸漂白水馬上就會潤透,可以馬上均勻漂白。第二是放進漂白水裡,就是次氯酸鈉,濃度大概2%左右,再擺到蒸餾水裡,將紙張上的次氯酸鈉沖洗乾淨,再移到硫代硫酸鈉裡,綜合紙上次氯酸鈉所殘留的氯。硫代硫酸納處理好後,再放到蒸餾水裡把化學藥品去除掉,再放到除酸液(碳酸氫鎂加一些黏劑)裡,讓紙張重新上膠,加強紙張纖維的黏結,並且脫酸。 製造脫酸液(碳酸氫鎂)時,是將碳酸鎂稀釋後放二、三天,與空氣中的二氧化碳接觸後,才會慢慢轉換成碳酸氫鎂,但為了要快速,可以直接在碳酸鎂液體裡,灌入二氧化碳氣體,10分鐘內便可變成碳酸氫鎂。若為考慮地球溫室效應,則製作碳酸氫鎂液體,沒有急迫需要的話,我建議採取前者方式。 無論是水淹書或是一些文獻資料淹水後,最重要的是,在處理修復後,都要有上膠的動作,因為紙張經過水的浸泡以後,紙張的膠會脫掉,所以要再幫它補充一些黏劑進去,就會恢復原來紙張的感覺。所以,上膠和脫酸都是很重要的一個步驟。  |
| (4) | 書頁在漂白液中情形:紙張前後要夾有化纖紙或是沙網,絕對不可直接觸摸書頁,因在潮濕的狀況下,如果觸摸它,紙張易壞掉,持拿時必須前、後夾著一張化纖紙或夾著一張棉紙,不要拿書頁本身,這個要特別小心。 |
| (5) | 書頁經過最後一道脫酸上膠處理後,取出放在吸水紙上涼乾。 |
| (6) | 涼乾後書頁需以木板夾住定型:在吸水紙上涼乾到約八、九成乾時,把每一頁對齊後,用木板夾住,效果就和裱褙字畫上板一樣。字畫裱褙是先托裱以後,把它上板,上板的目的是為了畫件繃平,而這是用壓平的,效果雖然沒有比繃平的好,但這種機製紙雙面印刷的,要上板繃平是非常困難,所以是用壓的方式。讓紙張平整有兩種方式:一種是上裱板,一種是採用壓的方式。若採用壓的方式,當紙是全乾的(此種情況指紙張纖維含有基本的含水量),再來壓它,那就無法壓平了,還是會皺皺的,所以要趁它快乾不乾的時候壓它,就會容易平整。 |
| (7) | 將定型後之書頁頓齊,於書腦處打三孔。 |
| (8) | 書身綴訂結線完成後,再與封面結合。 |
| (9) | 書身封面結合後,再以重物壓住定型,如用兩塊木板或上面擺一些重的東西壓平。有人做過實驗,說不要用機器的壓書機來壓書,因為機器壓書機的馬達力量非常大,在肉眼看不到下,壓書機在壓緊書的剎那間,紙張纖維中的水,被壓縮擠出纖維的速度和子彈一樣快。所以,機器壓書機對紙張纖維在壓的過程中,也會造成一種損害。 |
| (10) | 南海遺珠印譜漂洗前後情形之比較。  |
2. 單張文獻的水淹處理
單張文獻的處理程序都和整冊圖書處理的方式一樣。首先以畢業證書為例,這也是遭受象神颱風淹水,長了很多黴菌。
| (1) | 首先以軟性橡皮擦清理污損紙面。但濕性的黴菌長在紙面上,若直接用軟性橡皮擦清理,此刻紙張容易壞掉,所以須先以吹風機烘一烘,讓黴菌乾燥浮出紙面後,再用軟性橡皮擦處理,這樣可以減少對紙張的磨損。 |
| (2) | 將清理乾淨的證書噴濕潤。濕潤了以後(不可太濕),讓紙張攤平就好了。 |
| (3) | 將濕潤後的證書放入2%次氯酸鈉溶液中漂白10-30秒。 |
| (4) | 從漂白液取出後,再放入蒸餾水中清洗5分鐘以上。 |
| (5) | 從蒸餾水中取出再放入硫代硫酸鈉20g/L溶液中30分鐘以上,綜合紙上次氯酸鈉所殘留的氯。 |
| (6) | 由硫代硫酸鈉溶液中取出後,再放入蒸餾水中清洗5分鐘以上。 |
| (7) | 清洗後,取出證書,讓水分流出,再放入膠液中,補充漂白過程中所流失的紙張內部黏劑。 |
| (8) | 再由膠液取出,放在吸水紙上陰乾。 |
| (9) | 陰乾壓平後的情形:大約九成乾了,就擺在兩張紙中間夾乾,夾到全乾就會平整。記得快乾時一定要夾壓才會平;不夾壓,紙就會皺,等全乾以後,就很難處理了。 |




3. 漆布封皮黴菌的移除
當水淹過了以後,或庫房水氣很重的時候,我們會發現沒有淹到的漆布封皮書,也一樣會陸續長出黴菌,這是因為整個環境中的濕度很高,並且充斥著很多黴菌孢子,所以漆布封皮也就非常容易著生長黴。處理的方式如下:
我使用迪森這個藥劑,大概已經有10年了,在使用後的追蹤,目前迪森對漆布的色澤種種都還不至於有破壞的跡象。在以迪森處理後,會有一定的時效,如果藥效過了,書庫環境還無法改善,則處理過後的書籍,仍然會繼續長黴。所以,在處理黴菌書籍的過程中,除了書籍本身要處理外,書庫環境也要處理、清潔、改善,如此才能永遠抑制黴菌不要在書上出現。
| (1) | 依液體容量及200 ppm比例,秤出迪森藥劑需要數量。 |
| (2) | 配製200ppm藥劑:採用0.5公克溶於1公升水,因為濃度低,所以更安全。 |
| (3) | 以試紙測試藥劑pH為中性 |
| (4) | 以軟毛刷處理封面及書邊之表層黴菌灰塵情形。 處理長黴的漆布時,必須要有吸塵罩或集塵桌,把黴菌集中在集塵袋裡,不要讓它到處飛散。如果沒有集塵的設備,最好選一個天氣很晴朗的中午,到戶外陰涼、順風的地方處理,如果在逆風處刷,黴菌都會飛到工作人員的身上,也不要穿毛線衣類的服裝,因為容易沾附書上刷下來的黴菌。 將書皮上的黴菌用軟毛刷刷除掉,尤其是刷書的開書口時,要把書夾緊輕輕的刷,如果不夾緊,會把書頁紙張刷壞掉。  |
| (5) | 然後再以浸過抑黴劑的抹布,擦拭經軟毛刷處理過表層黴菌的圖書封面。 |
| (6) | 再以乾抹布,將漆布封面藥劑多餘水分,擦拭乾淨。 |
| (7) | 將擦拭乾淨的圖書,暫時按索書號排列整理存放於臨時典藏空間。 |
| (8) | 至於長黴菌的書架區,等到書籍封面的黴菌完全處理完,庫房空出來以後,再將那個區域的書架、環境重新消毒處理,並擦拭乾淨,再把處理好的書移回去。 |
4. 水淹後的書磚處理
水淹以後,很多書來不及搶救,等到發現時,已變成一塊塊的書磚了。處理書磚的方式,大概有下面幾種:
(1) 乾揭
係指書頁全部、局部輕度或中度黏結,紙頁尚能承受彎折揉動,而不至於斷裂。此法一般較適用於手工紙類書磚。首先用雙手食指及拇指捏住書的一端,一般先從無字處入手,如天頭、地腳或書背脊處,稍加反復彎折揉動,使書頁間鬆動後,再以竹刀或鑷子揭起。若仍堅硬如塊,則採濕揭。
(2) 濕揭
a. 淨水泡揭法:
首先將書磚放入淨水(電解水或蒸餾水)中浸泡,然後在水中將書頁分開取出陰乾。我比較喜歡用電解水,因為電解水是小分子的水,比較容易滲到纖維裡面,滲透力比較快。
b. 沸水泡揭法
以沸水加3%明礬,防止書頁黑色凐散,及2%廣膠加固紙頁,這就是膠礬水,浸泡一、二日,至書頁浸透後,再揭書頁。
(3) 蒸揭法
先用沸水將書浸泡,再將書以乾淨紙包起放入蒸籠內,蒸數小時,將書頁膠性溶化後,便可揭頁,必須隨蒸隨熱揭,不可冷揭,書頁一涼膠性變硬,則更不易揭開。這是傳統揭字畫、揭線裝書的方法。
(4) 真空冷凍乾燥法
此法國外使用較多,國內不普及。首先必須把書磚浸泡水中一、二天,再取出外包保鮮膜,放入冷凍櫃凍結,再取出放入真空器中,使凍結書磚固態之水分,直接氣化蒸發,使原本處於凍結狀態之書磚各頁間,形成空隙而分離。這個原理有點像燥揭法的原理。
(5) 酵素分解法
以酵素分解沾黏書頁間之澱粉類物質,使書頁間之沾黏度降低,並小於紙頁纖維間的聚合度,而將相互沾黏之書頁揭離,目前德、美、日、大陸及臺灣等地,也都有人在研究。如裱褙的字畫,背紙是用澱粉漿糊刷上去的,所以只要把裱褙的畫刷上α澱粉媒以後,裱褙的紙層很快就可揭離,因為α澱粉媒是專門分解澱粉的,而漿糊就是澱粉。所以針對膠加一些酵素,就可以把它分解。
(6) 燥揭法
這是我自創的一個方法,全世界目前好像都還沒有人使用。我們都知道成為書磚很久以後,紙張都很脆弱。燥揭法就是讓紙質脆裂的書磚,在苛性鈉(鹼性)裡浸泡,讓紙張纖維膨潤起來,再拿出來快速地乾燥,讓紙張和紙張分開。因紙張快速乾燥以後,紙張間的扭動方向都不一樣,就利用扭動方向的不一樣,兩張紙就分開了。這就是利用熱脹冷縮的物理原理,達到將紙分開的目的。
燥揭法:
原理1:參考物理熱力學第二定律中,有關克勞修斯說法「不可能把熱量從低溫物體傳到高溫物體而不引起其他變化」之原理,觀察大量多孔性固體材料,如紙張、紡織品等,在壓力保持不變時,由於溫度的改變,它們均會發生長度或體積的熱膨脹(thermal expansion)變化,以及纖維與液體接觸時,所出現因毛細現象(capillarity)而產生的附加壓強(也稱毛細壓強)等物理現象,作為燥揭法的基礎原理,來研究書磚的燥揭。 原理2:燥揭法是利用熱傳遞(heat transfer)方式,以急速高溫快速乾燥來改變紙張毛細現象中的附加壓強及熱膨脹係數,讓各張沾黏紙頁,相互產生不同脹縮力量,紙頁因受到同時發自各點非定向力量的作用,紙面便會形成波狀皺折,相互產生排斥而自動分開。此種利用熱傳遞產生脹縮力,而促使沾黏紙頁快速自行相互分開的方式,在揭頁的過程中,並不太需要人為外力的介入,操作簡易,書磚揭損率也幾近零。 原理3:熱傳遞(heat transfer)是改變系統內能的兩種方式之一,另一種方式為作功。在沒有作功而只有溫差的條件下,能量從一個物體轉移到另一個物體,或從物體的一部分轉移到另一部分的過程,稱為熱傳遞。熱傳遞又分為熱對流、熱傳導、熱輻射,實際上它們的傳熱方式,彼此有時也會同時存在,而增加了過程的複雜性,在燥揭法的程序中,所採取熱傳遞的方式,係以熱對流中的強迫對流方式,依靠外來快速加熱作用,使流體作循環流動,進而行熱量的傳遞,來達成燥揭書磚之目的。
四、圖書館水淹書搶救紀要
接著介紹兩個圖書館水淹書搶救案例。
(一)案例一
是93年10月22日臺北某圖書館二樓書庫淹水。淹水原因是天花板的水管破裂,這個水管是屋頂水槽的水管,漏水滴得整個書架,書籍都濕了。首先緊急處理,是先將屋頂水槽儲水緊急排放。還好是乾淨的自來水,如果像是象神、納莉颱風的水夾雜著污泥,那種水淹書就很難處理且又容易長黴。如果環境品質不好且處理不當,高溫下清水淹過的書也是會長黴,只是長黴的速度不會像髒水淹的那麼快。所以,要趕快將所有的書撤離書架,無法馬上撤離的,可暫時用塑膠袋將整個書架都蓋住,防止水管滴水繼續危害架上書籍。撤架的雪銅紙類水淹書籍,每一頁夾乾淨紙張,不然等書一乾,全部黏在一起,這本書就報廢了,等書頁夾紙張乾了以後,再用潮的布擦拭書頁,擦完後整本書壓一壓就非常平整。用潮布擦拭乾的書頁有一個作用,就是可以把紙張上的黴菌和一些泥垢擦乾淨,同樣的它可以賦予雪銅紙面一點水分,這樣乾燥後的雪銅紙才會展平,紙展平以後再壓,就會非常平整,也不會黏在一起。
(二)案例二
是93年6月25日某圖書館在遷館過程,有幾十箱西文書,因遷館來不及搬,暫放在一樓餐廳充當的臨時書庫,午後下了一場大雨,由於餐廳是低漥地區,結果整個地面上的書箱淹水,當發現時,已經是7月2日,過了八、九天了,由於臨時書庫是鐵皮屋,溫度非常高,很多書也都長黴。大概統計被淹的書有263冊,其中有92冊很嚴重,長了很多的黴及裝訂結構遭受破壞,輕微受損的有171冊。輕微的現在都處理好了,嚴重的部分目前只以迪森藥物處理控制局部的黴菌,因人力不足也還沒有修復。
1. 處理方式
本批水淹書的基本處理,包括移藏分類、圖書除濕及黴菌控制、書籍濕度檢測及記錄、簡易記錄、篩選裝箱。主要採用除濕的方式,是用移出處理,以自然通風方式除濕。將水淹書搬到四樓空處,進行移藏分類,將雪銅紙淹水嚴重的放在一區,道林紙、模造紙放一區,輕微的集中在一區,分為三部分處理。
接著將嚴重的書夾紙,讓書快一點乾燥,每天更換紙。嚴格來講,不能夾報紙,因為報紙本身木質素含量非常高,鉛含量也很高,所以一般是不用報紙的,但因當時的情況緊急,也沒有經費買一般的紙,而且夾紙的用量非常大,情非得已只好用報紙來權充了。
在四樓處理環境裡,開冷氣降低溫度,並噴灑400PPM迪森(天森)藥劑清潔環境,讓整個環境不要有黴菌滋生出來。實際上噴灑後,雖然沒有儀器檢測或作培養皿實驗,但用最原始的方式,以嗅覺發現整個環境的黴味降低很多,這也表示黴菌數正在減少中。在一個書庫裡,用鼻子的嗅覺聞,可以知道館藏發生了什麼問題,第一個味道是黴菌的臭味道,第二個味道是醋酸的味道,酒精的味道,第三種味道是酚香的味道。這三種味道都是因為圖書本身老化的過程或是被黴菌侵蝕的過程所產生出來的。如果到一個書庫就聞到很濃的黴菌臭味,就一定有黴菌產生。而酚香的味道是紙張木質素老化所產生的味道,很多書籍紙張裡有很多的木質素,年代比較久遠的書,大概四、五十年或五、六十年的書拿出來以嗅覺品聞,我們會發現這些書是很芳香的,人家說書香書香,實際上那不是好現象,書籍的酚香表示書已老化,是因書頁中木質素老化,散發出來的味道。還有一種味道是醋酸的味道,前面張豐吉教授所講的全纖維素,紙張是由全纖維素(包括半纖維素)、木質素所構成的。全纖維素老化所產生的味道,就是像醋酸的味道,所以用鼻子的嗅覺聞,就可以去檢測書庫到底出了什麼問題。用眼睛也可以檢測書庫出了什麼問題,如看書架上有沒有白蟻,有沒有蟲屎,有沒有蟲屍;如果有,就知道書庫有生蟲。
在處理的過程中,使用檢測紙張含水率的儀器,檢測一些水淹後的書籍的乾燥情況,因為有些濕的書,並不適宜上架典藏,雖然看起來好好的,摸起來也好好的,但當使用檢測器檢測時,發現書的含水量非常高,像這種會騙人眼睛的書,不要放到書庫去,一旦書庫的溫濕度沒有控制好,則這些未乾書就長黴了。測量書的濕度時,以測書背為主要部位,因為書背是最難乾的。
同時也會對有問題的書做簡單記錄,如記錄某年某月某日清潔過書籍的什麼地方,第幾頁清潔過,某年某月某日修補頂帶或其他的等。當隔天或過幾天後,再打開此書就可以知道,某年某月某頁處理的情況,再看看那一頁處理完以後,這幾天有沒有發生其他狀況出來。如果放了一個星期,處理過的部分都沒有變化,就可以把這本書歸架了。這簡單的記錄,沒有格式,只是空白紙,只記錄某年某月某日處理了什麼動作,如用迪森(天森)處理封面的黴菌,某年某月某日過了一個星期以後,再觀察黴菌有沒有長出來,如有長出來,表示處理有問題,不能放到書庫;若沒問題就將書篩選裝箱,就是天天用比對、檢查的方式,將沒問題的書籍裝箱,準備搬遷。
2. 損壞修理及黴污移除
在本案例中所採取的幾種簡易修復方式:
(1) 塑膠封套縮小處理
在處理那批水淹書時,有很多讓我們想像不到的損壞。我們檢測到的書,有些書是塑膠皮的封面,會縮小,一旦封皮縮小後,封面的厚紙板就不容易套進塑膠皮封面內,這時可以用熱風機把塑膠皮封面吹軟化後,將它延伸拉開來,再把封面紙板套進塑膠皮封面內,再以重物壓平,等冷却後,書就平整了。大概可以維持一、兩年的時間。如果過一、兩年以後,塑膠封皮又收縮了,再用這方法處理,處理幾次以後,就會彈性疲乏,不會收縮了。
(2) 頂帶脫落
另外,我們發現水淹書的頂帶(也叫花頭布)會脫落掉。在中古世紀的頂帶,是縫在書身各書組上,現在為了美觀,全都是黏貼上去的,所以遇水會掉。遇到此種狀況,我們就照原來裝訂的方式,用白膠黏貼回去。
(3) 開書口浮黴移除
還有一種情況是,這本書都非常完好,但是底部開書口長黴。我們用薄砂紙稍微把黴菌磨擦掉,但不能磨太多,因為書會變小,只要稍微磨掉表層就好了。另外,開書口水漬的處理是一項大工程,要把每一頁拆開漂白。因為水漬是深到書頁裡面的,整個磨掉書身會變得很小,等於切掉一樣。在表層的黴菌磨掉前,須先用熱風機吹,讓黴浮起來,再磨會比較好磨。我們也會寫一個記錄放在旁邊,一個星期後,看磨過的部位,會不會再長出黴菌來,如果這一個禮拜環境維持得還不錯,沒有長出來,就將它放到書庫。水淹書是一個不定時炸彈,即便處理好移入書庫典藏以後,還是需要定期或不定期去書庫看一下,若有產生變化,代表書庫有問題。如果圖書館有更好的除黴菌設備,在處理完水淹書乾燥修復等問題以後,最好再做一次黴菌的燻蒸處理。
(4) 封皮簡易裝回
還有發現很多水淹書的書皮脫落了,要裝回去時發現長黴,也是用吹風機把黴吹浮出來,再用軟毛牙刷把書溝的黴刷掉,刷掉後,照原來的方式再把封面裝回到書身上。
(5) 封面浮黴移除
我們發現很多書的漆布封面或是布面封面,在經過水災後,很容易長黴,用很簡單的東西,例如依必朗的濕紙巾,配合200PPM的迪森噴在濕紙巾上,輕輕擦拭。還有一種情況是淹水後,漆布封皮會脫膠浮起離開紙板,修復的方式是必須重新把封面拆開,換掉紙板,再把封皮拉平,刷膠重做。
(6) 書頁浮黴移除
布面的書封雖然沒有淹到水,但由於是放在箱子裡,濕氣也會造成它長黴菌,處理後雖然不能完全恢復到乾淨,但基本上已經恢復了,必須要再放一個星期,觀察處理後是否還會繼續長黴。還有書頁周邊水淹造成部分很皺,處理方式是拿不織布沾迪森藥水,每一頁擦拭,先將黴菌去除掉,每頁最多只能擦3次,因為擦多了書頁表面會起毛,擦3次後紙張就平了,全部擦好以後,再壓平,整本書也就平整了。所以,乾的、書頁很皺的書,經過擦拭重壓後,不平的書籍就會變比較平了。雖然不可能像原來的書那麼平,但基本上用肉眼看,就覺得它是平了。
(7) 脫頁及封面修補
有一本水淹書,因為在紙箱中是直擺的,被很多重的東西壓下來,整個書身就變成了S型,這種比較難處理。當然是要把封面和書拆開,逐頁清洗、漂白,再用壓的方式處理。
五、結論
水淹書的搶救,雖然無法百分百恢復它被淹前的容貌,但大部分卻是可以再救回被繼續使用。如果有複本或可以再買到,認為可以丟棄也無妨,但是很多水淹書,是根本買不到的,因為是絕版書。所以,丟棄是處理水淹書最便利的方法,但也是人類文化被破壞最徹底的方式,無心的丟棄處理,我們可以體諒,但為省卻麻煩而有意丟棄,是不道德的事情,因為人類的文化,不能隨便的丟棄。
最後介紹本館最新的除酸設備,這套設備原是加拿大韋陀法經改良以後,變成德國貝特法。背面有幾個鐵桶,一個鐵桶是放藥劑的,一個鐵桶放溶劑,將藥劑和溶劑混合變成除酸液,另外一個鐵桶是回收脫酸以後的液體。我們是用鎂醇和鈦醇兩種藥劑,和有機溶劑矽油混在一起變成除酸液,是屬於一種濕式除酸的方式。濕式除酸,一般在早期來講,是用水加上除酸的藥物變成除酸液,但是在大量除酸時,用水做除酸液會有一些缺點,就是書不容易平整,不容易脫乾,所以才用溶劑的方式來克服水的缺點。
下圖是真空幫浦的馬達,可以將除酸空間達到0.5 Tarr真空狀態。這是一套全部由電腦控制整個除酸的作業流程,如藥劑的混合、回收,還有處理過程中的危險警示等,全部由電腦發出信號,全部由電腦控制。



我們到德國廠驗這套除酸設備時,這是臺灣大量除酸所做出來的第一批脫酸書籍,首先將書放到真空室後﹙圖A﹚,灌上除酸液,就是鎂醇、鈦醇、矽油混合在一起的除酸液﹙圖B﹚,書頁印刷部分易暈開的,就夾一張紙隔離吸附,我們發現它暈開的非常少,幾乎肉眼看不到﹙圖D﹚。還有將pH4.5的酸性紙一起擺進去除酸,經過除酸後,用pH值測試筆畫線測試,該線條為藍色,大概pH8.5左右,另一張沒有除酸pH值4.5的紙,畫過的線條是呈現黃色的﹙圖C﹚。這兩張紙是很有歷史意義的,當時一除酸出來以後,就請所有參與的德國專家及本館人員簽名紀念,百年以後,可以做個除酸後和未除酸保存效果的對照,同時也足以堪慰地告訴我們的後輩說:「這是百年前臺灣第一台也是亞洲第一台同型大量脫酸機,在德國所做的試驗品,在世界保存酸性紙的作為上,你們前輩是並未留白的。」。
 圖A
圖A 圖B
圖B 圖C
圖C 圖D
圖D貳、圖書光害防治
一、光的產生
要了解如何防治紫外線,對光就要有基本認識,了解光是如何產生的。光是由發光體所發射出的輻射線、電磁波,按其發光體之不同,一般分為自然光與人為光兩種,自然光係指從太陽發射並到達地球表面的光;如果發光體是人為製造出來的,如電燈,就是人為光。
二、光的波長
光根據波長(nm)的不同,可分為可見光和不可見光二種。可見光是人類視覺可感受到的,一般分為紅、橙、黃、綠、藍、靛、紫七種顏色,波長約在400-760nm,有的說是380-780nm。不可見光是人類視覺無法感受到的波長,一種是760-3000nm的紅外線光,另一種波長在400-290nm的是紫外線光。其中,紫外線光對人體皮膚或對紙張,都是在無形中產生破壞的。依各種波長光波的能量,整理如表1。
表1、各種波長光波的能量
| 光的種類 | 波長(nm) | 能量(千卡/克分子) |
|---|---|---|
| 短波長紅外線 | 1000 | 28.6 |
| 可見光的極限 | 800 | 35.7 |
| 紅 | 700 | 40.9 |
| 黃 | 600 | 47.6 |
| 藍 | 500 | 56.9 |
| 可見光的極限 | 400 | 71.5 |
| 長波長紫外線 | 300 | 95.3 |
| 紫外線 | 200 | 143.0 |
| 短波長紫外線 | 100 | 286.0 |
(資料來源:檔案保護與復製技術學)
三、光對纖維抗張強度的破壞
各種波長的光都有能量,從表1顯示,波長nm越大的,能量越小;到波長100nm時,短波長紫外線的能量最大286。能量越大,穿透紙張時,造成紙張纖維破壞程度最大。當然所有的光都會破壞紙張,在可見光和不可見光中,破壞最嚴重的是400nm以下的光,紫外線雖僅占5%以下,但其破壞力卻是最大的,即使在各種人為光源中,也都含有一定比例之紫外線,紙張、色彩、纖維物質易受紫外線分解氧化,尤其經過光降解後會降低纖維間聚合度,進而影響圖書紙材的吸濕性及含水率降低,而促使紙纖維硬化、分裂,失去纖維固有耐折強度,若有氧氣存在,也會因光合水解作用,而產生化學反應,促使紙質迅速破壞,實驗證明紡織品遭受陽光三個月不斷照射,紡織品便會喪失耐久性95%,紙質尤甚,而天然麻經200小時照射、亞麻經999小時照射、棉經940小時照射、羊毛經1129小時照射後,各種纖維素的機械強度,也都會比原來降低50%。(見表2)
表2、光照對不同強度棉纖維抗張強度之影響
| 棉纖維樣品編號 | 實驗前抗張強度(克) | 20天光照後抗張強度 | 抗張強度降低(%) |
|---|---|---|---|
| 1 | 262 | 212 | 19.0 |
| 2 | 259 | 180 | 30.0 |
| 3 | 226 | 146 | 36.0 |
表3、紙張照射後紙質分析結果
| 照射劑量(KGY) | 抗張強度 | 撕裂強度 | 破裂強度 | 白度 |
|---|---|---|---|---|
| 0 | 29.4 | 9.18 | 1.83 | 35.9 |
| 0.5 | 29.3 | 8.67 | 1.96 | 36.6 |
| 1 | 29.1 | 9.83 | 1.93 | 36.1 |
| 10 | 29.6 | 8.99 | 1.86 | 36 |
| 25 | 28.5 | 7.88 | 1.87 | 35.7 |
| 100 | 25.0 | 7.09 | 1.62 | 34.3 |
| 250 | 22.3 | 3.96 | 1.09 | 33.3 |
四、光的照明單位
(一)燭光(Candle)或燭光功率(Candlepower)
一般發光體的發光強度,稱為燭光。光度單位簡稱C或Cp,以量度一光源在某一方向上之發光強度,以一支蠟燭在其水平方向上之光度約一燭光。如電燈泡是一個發光體,發光強度有六十燭光或一百燭光。
(二)流明(Lumen)
流明,光束單位簡稱Lm,以量度一發光體所輸出之光量(或稱光束),就是光線從發光體發出的光線到桌面所輸出的光亮。一支向四周發出一燭光光度之發光體所輸出之光束為4π(12.57)Lm。
(三)呎燭(Footcandle)
當流明照到桌面時,稱為照度、呎燭。照度單位簡稱Fc。一流明光束照在一平方呎之工作面上所造成之照度為一呎燭。呎燭係英制單位,一呎燭約等於公制單位十勒克司(Lux)。圖書館所要注意的是照度問題,常常因為書架排列的方式、光源的方式的不同,照度也不同。同樣的,發光體照在這邊的照度和照在那邊的照度是不一樣的。所以,圖書館所要求的是在書架面、書籍上的照度,還有閱覽室是要求桌面的照度,而不是要求整個環境的照度。
(四)照明率(Coefficients of Utilization)
照明率或稱效用係數,簡記Cu,是指到達工作面之流明數(即產生有用之呎燭)對發光體所發出流明數之比。
五、圖書館的光照標準
光照時間愈長對圖書紙張的破壞也就愈大,由保護與利用的角度來看,如何設計書庫的光照,是非常重要的事情,照度既要滿足調書與上架的需求,同時也要顧慮圖書吸光後的損害,因此書庫內基本照度的設計原則,是以工作時能看到圖書書名及不傷害管理人員視力之最少照度為標準,以下各表為臺灣及各國照度需求標準,可供實際工作時參考。
表4、國外圖書館照度標準(單位:勒克斯)
| 照明場所 | 書庫 | 閱覽室 | 小閱覽桌 | 辦公室 | |
|---|---|---|---|---|---|
| 歐洲 | 法 國 | 54─108 | 54─86 | 130─270 | ─ |
| 波 蘭 | ─ | 54─108 | 108─216 | ─ | |
| 英國照明工程學會 | ─ | 75 | 183 | 102─216 | |
| 美國 | 照明工業會 | 108 | 320 | 325 | 540 |
| 喬治亞工業大學 | 300 | 485 | 485 | 645 | |
| 日本 | 國立國會圖書館 | 50─100 | 250 | 250 | 250 |
表5、大陸國家檔案局和城鄉建設環保部制定照明標準
| 名稱 | 檔案庫 | 閱覽室 | 出納台 | 修裱編目室 | 電腦主機房 |
|---|---|---|---|---|---|
| 推薦照度(勒克斯) | 不低於50(檔案台、架的垂直面) | 不低於150 | 不低於100 | 不低於150 | 不低於200 |
表6、美國不同年代照度標準
| 室名年代 | 書庫 | 閱覽室 | 期刊室 | 工作室 |
|---|---|---|---|---|
| 1931 | 17 | 108 | 108 | 108 |
| 1932 | 32─43 | 80─108 | 80─108 | 80─108 |
| 1937 | 54 | 215 | 215 | 323 |
| 1938 | 54 | 323 | 215 | 215 |
| 1941 | 54 | 323 | 323 | 323 |
| 1947 | 54 | 269 | 269 | 269 |
| 1949 | ─ | 215 | 215 | 215 |
| 1952 | ─ | 323─538 | 323 | 323 |
| 1956 | 54─108 | 323─538 | 323 | 323 |
六、圖書館的光害防治
圖書館書庫建築的防光,基本考量是以建築物窗戶在設計上,宜小而少,東西壁面不宜開窗,為避免陽光直射入庫,可在窗戶設置遮陽措施,例如窗簾、有色玻璃、黏貼膠膜、遮陽板等,以緩和陽光直射問題,改善圖書館的典藏環境。
(一)自然光的防治
如有室內氣溫常在攝氏29℃、太陽輻射強度大於240kcal∕㎡時、陽光照射室內深度(由牆內表面積算起)大於 0.5公尺、或陽光照射室內時間超過1小時等情況發生時,便應考慮設置適當之遮陽措施。自然光的防治一般概分三種方式:1. 利用綠化遮陽;2. 結合建築構件處理遮陽;3. 專設物遮陽。
1. 利用綠化遮陽
用綠化也可以遮陽,如窗外種植大樹、窗台植盆栽、牆壁面植爬藤,可以降低室內的溫度,也是減少光線直射的一些措施。如臺灣分館在新生南路的館舍,可以看到有一面窗戶外有種植一大排高大的樹,不但可以防止西曬,還降低書庫的溫度。
2. 結合建築構件處理遮陽
在建築時,可以直接在建築物外方,設計一些遮陽的措施,如下圖的方位表,顯示東邊是擋板式的遮陽,西邊也是擋板式的遮陽。如臺灣分館的新生南路館舍的窗戶旁邊都是凸出來的水泥柱,就是垂直式的遮陽方式。






3. 專設物遮陽
自然光的防治方式,除了前二項外,還可以在窗戶上做一些措施,如加裝窗簾、塗上紫外線吸收劑、使用有色玻璃、黏貼膠膜等。加裝窗簾又可分為透光和不透光二種,如加裝一般透光窗簾可以稍微過濾一些紫外線,但又不影響光線;又加裝不透光的窗簾,光線幾乎透不過,可以直接把光線斷絕。
在有色玻璃之使用前,應先了解陽光照射玻璃窗表面時,一部分光線會被反射,一部分會被玻璃吸收,剩餘部分則直接透射入庫內,這三分量之相對比例,係取決於玻璃種類、厚度及射線入射之角度;而光譜的透過率,則決定於玻璃之化學成分、顏色及其深淺,以及特殊的表面塗料。
至於選用何種玻璃,圖書館自應有所考量。就以玻璃顏色而言,應避免使用無法有效吸收紫外線之藍、紫色,而宜用紅、黃、綠等色玻璃,則可避免過多紫外線照射於圖書之上。目前市面已有專門生產防紫外線之玻璃,如不嫌麻煩也可於玻璃上黏貼F-H(SK-eau)膠膜,或自製紫外線過濾塗料,以2:1比例之白鉛粉與桐油相混合,再用汽油稀釋後,塗抹玻璃以過濾部分紫外線。
表7、SK-eau膠膜功能表
| 用途 | 一般性能 | 特性 | ||||||||||||||||||||||
|---|---|---|---|---|---|---|---|---|---|---|---|---|---|---|---|---|---|---|---|---|---|---|---|---|
| 用來黏貼建築物表面之玻璃帷幕或玻璃窗上,具有防止紫外線及災害時玻璃碎片四處飛散。 | 紫外線吸收率達99.5%以上、防止災害時玻璃碎片之四處飛散符合JIS規定、保護玻璃表面、強化玻璃強度。 |
|
(二)人為光的防治
一般處理人為光的方式有過濾與斷絕兩種方式單獨使用或併用。
1. 過濾方式,是將發光體所放出光線予以選擇性阻擋,如使用紫外線吸收膜,把所有的紫外線光源,如電燈泡、窗戶等直接黏貼,可以過濾紫外線的光。 2. 斷絕方式,是將發光體之功能予以暫時性關閉或永久性去除,如一個自動式的開關,人只要一進去燈自動打開,人走了自動關閉,這也是一種斷絕方式。
由於人們平常較難感受紫外線之存在,便誤認為只有陽光中才有紫外線,而忽略了人工光源之日光燈在開啟時,內部汞原子會電離發射出波長為253.7nm之紫外線,刺激管壁上螢光粉,而發出可見光,有一部分紫外線便會透過燈管輻射出來,其輻射量足以對圖書構成嚴重威脅。書庫如用日光燈為光源主體時,則一定要採取預防紫外線措施,例如紫外線吸收劑之塗抹、日光燈罩及照明自動控制之安裝等。依據國立故宮博物院對日光燈罩所做研究,得知磨砂玻璃燈罩對紫外線吸收甚小,約有60%紫外線仍可透過,普通壓克力燈罩對紫外線吸收較強,但仍有25%之紫外線可透過,特製壓克力板較佳,尚能透過15%之紫外線。雖然特製壓克力板可濾去日光燈中85%紫外線,但仍未理想,圖書如在此種環境中,長期接受15%紫外線照射,仍會積少成多,而吸收大量紫外線,若每個紫外光之光子,可分解紙中一個葡萄醣分子,則以普通螢光燈照射紙張二十年,紙張便會完全分解,若用特製壓克力板濾光,紙張壽命則可增加二百年,此種估計並未考慮紙張之吸光性質及空氣中氧化作用等因素,所以並不精確,僅供參考,故使用磨砂玻璃為燈罩者,應及早捨棄,改代以特製壓克力板或紫外線吸收玻璃,以減少圖書遭受紫外線之傷害。

▲國立中央圖書館臺灣分館楊時榮先生(編輯組提供)
關於白熱燈泡所發出可見光成分中,長波光譜強,短波光譜弱,與自然光比較略呈紅色,紫外線含量極微,對圖書在紫外線影響上有限。若書庫規劃時,在燈光設置上便有萬全設計,而作有效控制,並以白熱燈光取代日光燈,同時燈光裝設位置,亦需予以控制,以防光源直射架上損傷圖書。至於已裝置螢光燈設備之書庫,可予以補救裝置過濾燈罩於燈管外,此種燈罩在換新燈管後,仍可繼續使用,既省錢且耐用。還有一種更經濟之辦法,便是將書庫中,凡不需經常使用之處所,及無人在場時,均予以隨手關燈,或加裝照明自動化控制系統,利用各種自動化控制設備,如紅外線偵測器、感光器、遙控器等,搭配微電腦中央系統及微處理器,使照明控制系統可以自動點滅(On/Off)或調光(Dimming),以滿足書庫防治長時間光照之需求。照明自動化控制系統之點滅方式,便是控制燈光的開與關,而調光方式,則是於燈光開啟後調節其明亮程度,其兩種方式之執行,均靠預程控制、人員感知、晝光利用、模式設定等四種方式設定執行(見圖1)。圖書館依各部門需求的不同,可利用上述四種方式相互配合使用,使手動控制照明不當的能源消耗能夠避免,並能創造更好的光環境。但書庫以保護文獻之立場而言,係有儘量減少光照之需求,所以無論是自動點滅或調光,都以人員感知方式設定執行較為適宜(圖2、3)。
圖1、照明自動化控制系統

(資料來源:學校教室照明自動化技術手冊及教室照明規範之研訂)
圖2、自動點滅人員感知控制動作及流程

利用紅外線偵測器或光電感測器來測定人員在室情況,是否有人員活動,並依其檢測區域來執行點滅控制,需注意要有適當延遲時間,以免對人員產生不舒適感。
(資料來源:學校教室照明自動化技術手冊及教室照明規範之研訂)
圖3、自動調光人員感知控制動作

人員感知自動調光系統與自動點滅系統之構成原理相同,均是利用紅外線偵測器測定室內是否有人員活動,而自動調整光源。然所不同的是自動點滅系統在無人員活動時,將活動區內之光源完全熄滅,而自動調光系統則依設定之不同,在無人員活動時,會將活動區內之光源,依設定不同仍可保有5%─50%之環境照度,不致形成一片漆黑空間。
(資料來源:學校教室照明自動化技術手冊及教室照明規範之研訂)
七、結論
為有效控制書庫內紫外線傷害,除安裝白熱光燈、自動點滅調光系統,或在現有螢光燈及窗戶加裝紫外線過濾器材外,在窗戶裝置適當遮陽板,亦可防止陽光直射入庫,減少部分圖書受損。所謂「遮陽」,就是使建物窗口處於陰影中之措施,其方式很多,依其類型、材料的不同而迥異。如屋頂的深出檐,上層的挑陽台,或外廊、窗戶花台,以及各種材料、形式的窗簾、布篷、植栽等,都有防止直射陽光、避免產生眩光、改善室內熱環境,以及加強建築外觀藝術效果與美化等作用,因此,設計窗口遮陽時,應兼顧遮陽、採光、通風、冬季日照以及擋雨多方面之要求,不可盲目追求建築物立體造形美觀而濫用。固定永久遮陽板之基本形式,計有水平式、垂直式、綜合式與擋板式四種。
所以,如何防止庫房,遭受陽光直射及人為光源中之紫外線傷害,必須要有周詳規劃與設計,以有效控制自然及人為光源,如此當可儘量減少圖書受紫外線傷害之程度,提高圖書館典藏安全率。